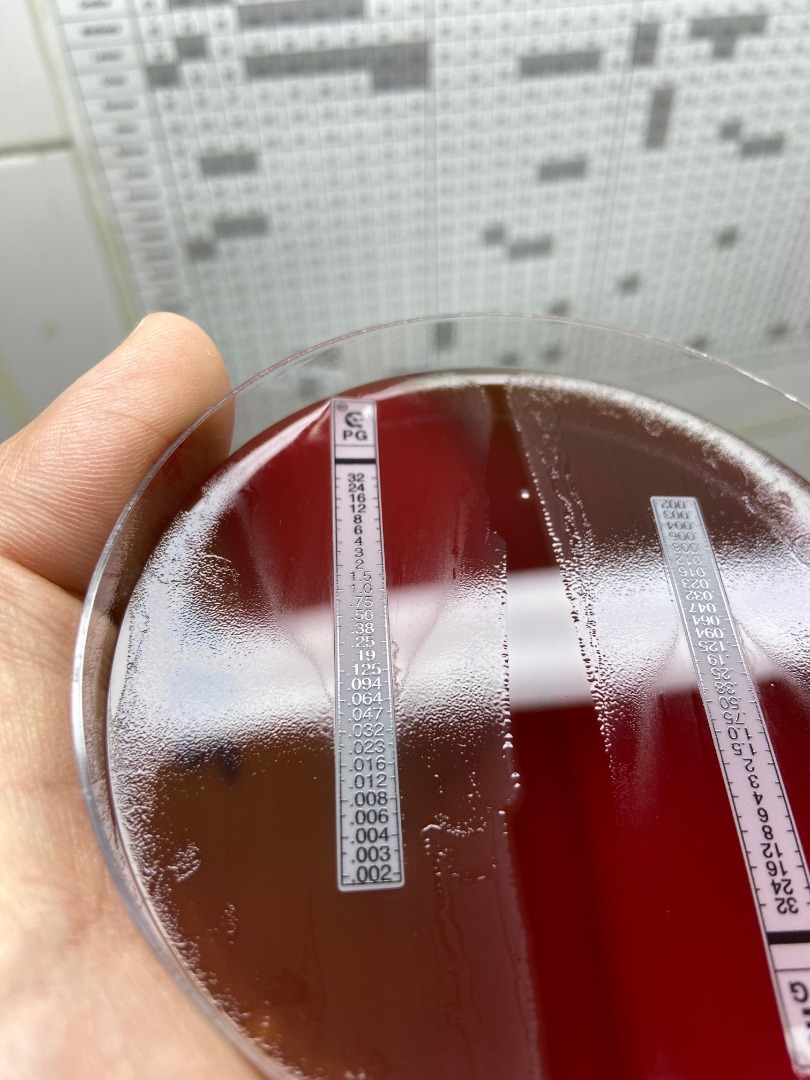
220820254.jpeg

Notícias
Pesquisa da UFPB aponta maior resistência de bactéria comum em gestantes

Você pode não conhecê-la pelo nome, mas a Streptococcus agalactiae é uma bactéria que causa infecções graves em segmentos vulneráveis da população, como gestantes, idosos e recém-nascidos. Estima-se que entre 10 e 30% das mulheres tenham esse micro-organismo, também conhecido como streptococo do grupo B (GBS), que pode acabar passando para o bebê na hora do parto natural.
Nesse cenário, uma pesquisa da Universidade Federal da Paraíba (UFPB), em parceria com a Universidade de São Paulo (USP), coletou 101 amostras da bactéria no Hospital Universitário Lauro Wanderley, em João Pessoa, entre 2018 e 2022, e constatou um dado preocupante: mais de 80% das amostras apresentaram resistência a algum antibiótico, destacando-se a tetraciclina, a eritromicina e a clindamicina.

Uma hipótese dos investigadores, que será melhor desenvolvida em outros estudos, é de que o uso indiscriminado de antibióticos durante a pandemia de covid-19 possa ter provocado o aumento de resistência dessas bactérias.
Como explica um dos autores da investigação, o professor Vinícius Perez, do departamento de Ciências Biomédicas da UFPB, pesquisas como essa são fundamentais devido à escassez de dados sobre o streptococo do grupo B, sobretudo no Nordeste brasileiro. “O próprio governo federal reconhece isso, e dados são fundamentais para elaboração de políticas públicas eficazes”, diz o especialista. Assim, algumas estratégias de prevenção envolvem ampliar o número de pesquisas para avaliar o comportamento da bactéria em diferentes regiões.

Atualmente, a estratégia para prevenir esse tipo de infecção no parto consiste em fornecer antibióticos para gestantes que tiveram bactérias identificadas em seu organismo. “O problema é que a recomendação governamental é que apenas mulheres em gestação de alto risco façam a investigação desse micro-organismo. E é comum a bactéria estar presente em mulheres com gestações normais”, explica o professor, que recomenda a testagem universal em mulheres grávidas.
Outra iniciativa para enfrentar a questão é o desenvolvimento em curso de uma vacina contra variantes dessa bactéria. “Os dados obtidos em estudos como o nosso podem então eventualmente servir para ajudar na elaboração dessas vacinas", afirma Perez.
No momento, os pesquisadores continuam investigando o streptococo do grupo B, mas se debruçando sobre formas de infecção que ocorrem após o parto, entendendo, por exemplo, como a bactéria se comporta no nariz e em outros órgãos do corpo.
* * *
Texto: Hugo Bispo
Fotos: Vinícius Perez/Arquivo Pessoal
Ascom/UFPB
